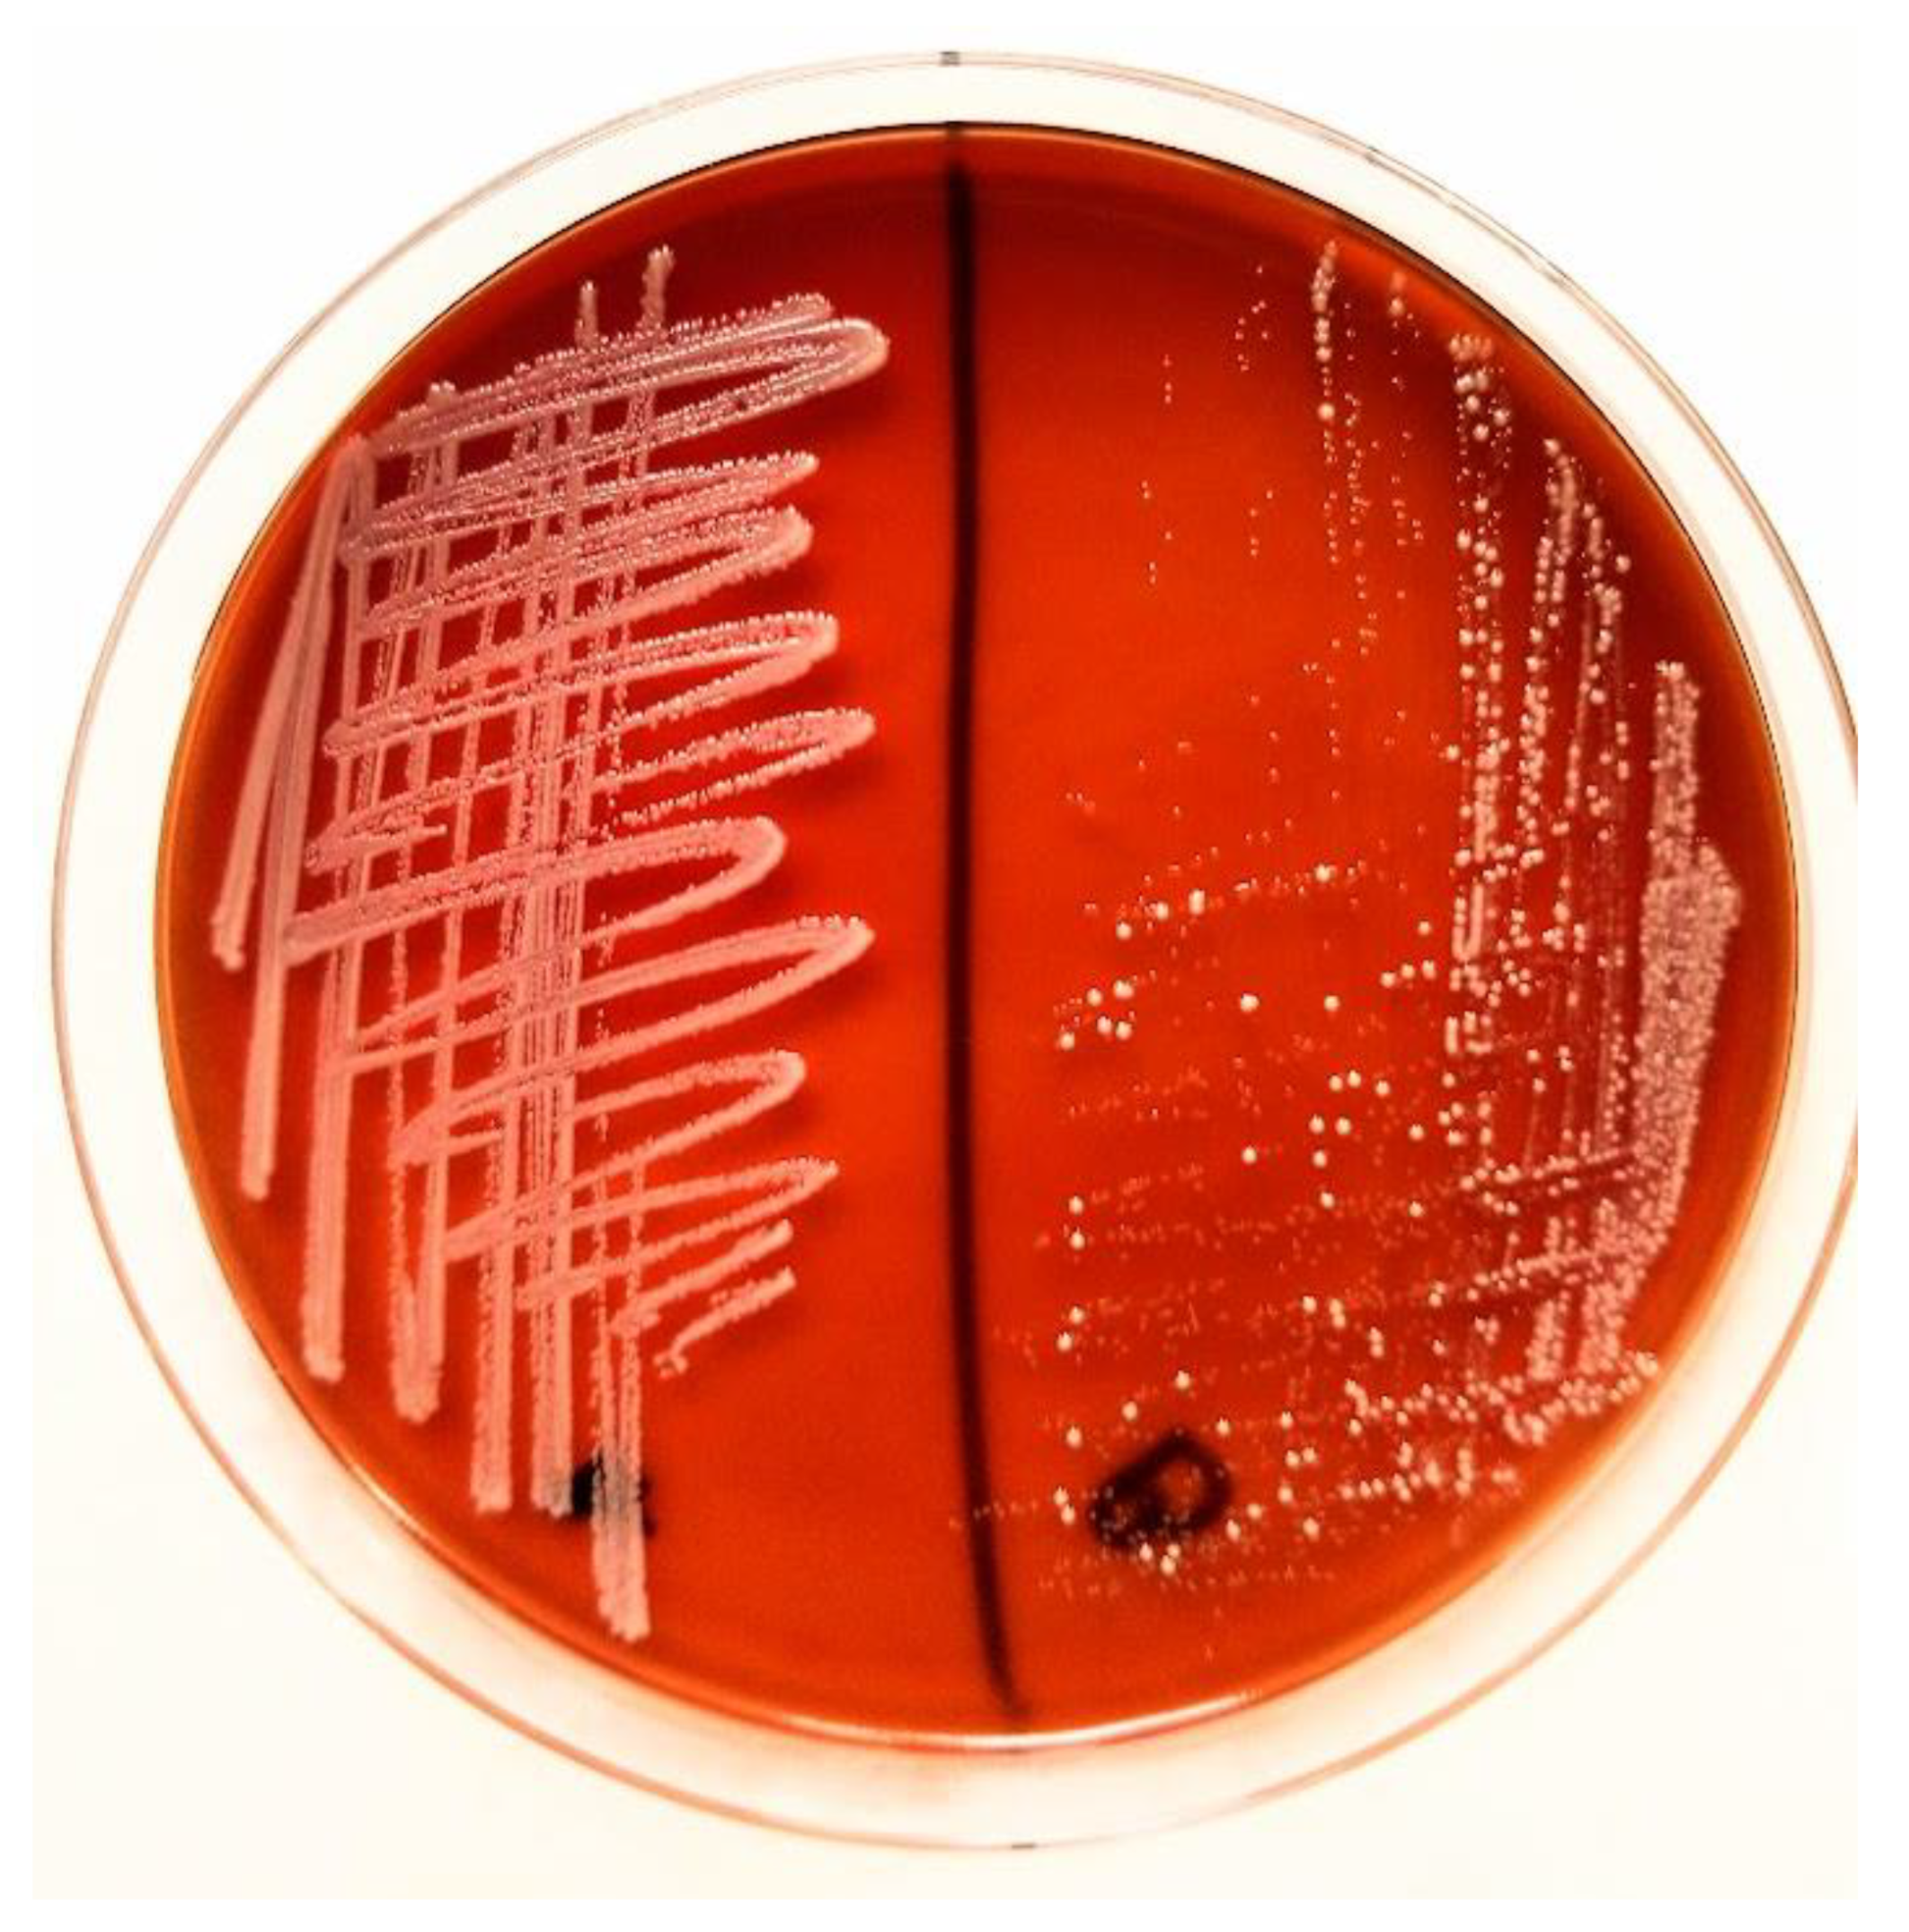
Antibiotics 14 01089 g002 Antibiotics 14 01089 g002

First Report of Multidrug-Resistant Staphylococcus sciuri Isolated from the Urinary Bladder of a Domestic Rabbit in Romania: A Case Study
Abstract
1. Introduction
2. Case Study
3. Discussion
4. Conclusions
Author Contributions
Funding
Institutional Review Board Statement
Informed Consent Statement
Data Availability Statement
Acknowledgments
Conflicts of Interest
References
- Cooper, S.C.; McLellan, G.J.; Rycroft, A.N. Conjunctival flora observed in 70 healthy domestic rabbits (Oryctolagus cuniculus). Vet. Rec. 2001, 149, 232–235. [Google Scholar] [CrossRef]
- De Vos, P.; Garrity, G.M.; Jones, D.; Krieg, N.R.; Ludwig, W.; Rainey, F.A.; Schleifer, K.-H.; Whitman, W.B. (Eds.) The Firmicutes. Bergey’s Manual of Systematic Bacteriology; Springer: New York, NY, USA, 2009; Volume 3. [Google Scholar]
- Hauschild, T.; Stepanović, S.; Zakrzewska-Czerwińska, J. Staphylococcus stepanovicii sp. nov., a novel novobiocin-resistant oxidase-positive staphylococcal species isolated from wild small mammals. Syst. Appl. Microbiol. 2010, 33, 183–187. [Google Scholar] [PubMed]
- Kloos, W.E.; Schleifer, K.H.; Smith, R.F. Characterization of Staphylococcus sciuri sp. nov. and Its Subspecies. Int. J. Syst. Evol. Microbiol. 1976, 26, 22–37.ibility Pattern. [Google Scholar] [CrossRef]
- Lowy, F.D. Staphylococcus aureus infections. N. Engl. J. Med. 1998, 339, 520–532. [Google Scholar] [CrossRef]
- Kawano, J.; Shimizu, A.; Saitoh, Y.; Yagi, M.; Saito, T.; Okamoto, R. Isolation of methicillin-resistant coagulase-negative staphylococci from chickens. J. Clin. Microbiol. 1996, 34, 2072–2077. [Google Scholar]
- Stepanović, S.; Vuković, D.; Trajković, V.; Samardžić, T.; Ćupić, M.; Švabić-Vlahović, M. Possible virulence factors of Staphylococcus sciuri. FEMS Microbiol. Lett. 2001, 199, 47–53. [Google Scholar] [CrossRef]
- Monecke, S.; Ruppelt, A.; Wendlandt, S.; Schwarz, S.; Slickers, P.; Ehricht, R.; Jäckel, S.C. Genotyping of Staphylococcus aureus isolates from diseased poultry. Vet. Microbiol. 2013, 162, 806–812. [Google Scholar] [CrossRef] [PubMed]
- Holmes, M.; Harrison, E.; Fisher, E.A.; Graham, R.; Parkhill, J.; Foster, G.; Paterson, G.K. Genomic Analysis of Companion Rabbit Staphylococcus aureus. PLoS ONE 2016, 11, e0151458. [Google Scholar]
- Ito, T.; Hiramatsu, K. Acquisition of methicillin resistance and progression of multiantibiotic resistance in methicillin-resistant Staphylococcus aureus. Yonsei Med. J. 1998, 39, 526–533. [Google Scholar] [CrossRef]
- Yasuda, R.; Kawano, J.; Matsuo, E.; Masuda, T.; Shimizu, A.; Anzai, T.; Hashikura, S. Distribution of mecA-harboring Staphylococci in Healthy Mares. J. Vet. Med. Sci. 2002, 64, 821–827. [Google Scholar] [CrossRef]
- Paul, G.C.; Friend, D.G. Case report: Disseminated Staphylococcus aureus infections in two infant desert cottontail rabbits (Sylvilagus audubonii). Wildl. Rehabil. Bull. 2024, 42, 10–16. [Google Scholar] [CrossRef]
- Stepanović, S.; Ježek, P.; Vuković, D.; Dakic, I.; Petráš, P. Isolation of Members of the Staphylococcus sciuri Group from Urine and Their Relationship to Urinary Tract Infections. J. Clin. Microbiol. 2003, 41, 5262–5264. [Google Scholar] [CrossRef]
- Stepanović, S.; Dakić, I.; Djukić, S.; Lozuk, B.; Švabić-Vlahović, M. Surgical wound infection associated with Staphylococcus sciuri. Scand. J. Infect. Dis. 2002, 34, 685–686. [Google Scholar] [CrossRef]
- Russo, T.P.; Borrelli, L.; Minichino, A.; Fioretti, A.; Dipineto, L. Occurrence and Antimicrobial Resistance of Staphylococcus aureus Isolated from Healthy Pet Rabbits. Vector Borne Zoonotic Dis. 2024, 24, 159–165. [Google Scholar] [CrossRef] [PubMed]
- Pipová, M.; Jevinová, P.; Kmeť, V.; Regecová, I.; Marušková, K. Antimicrobial resistance and species identification of staphylococci isolated from the meat of wild rabbits (Oryctolagus cuniculus) in Slovakia. Eur. J. Wildl. Res. 2012, 58, 157–165. [Google Scholar] [CrossRef]
- Abdallah, R.; Mostafa, N.Y.; Kirrella, G.A.K.; Gaballah, I.; Imre, K.; Morar, A.; Herman, V.; Sallam, K.I.; Elshebrawy, H.A. Antimicrobial Effect of Moringa oleifera Leaves Extract on Foodborne Pathogens in Ground Beef. Foods 2023, 12, 766. [Google Scholar] [CrossRef]
- Clinical and Laboratory Standards Institute (CLSI). Performance Standards for Antimicrobial Susceptibility Testing, 34th ed.; CLSI Supplement M100; Clinical and Laboratory Standards Institute: Wayne, PA, USA, 2024. [Google Scholar]
- Thomas-White, K.; Brady, M.; Wolfe, A.J.; Mueller, E.R. The bladder is not sterile: History and current discoveries on the urinary microbiome. Curr. Bladder Dysfunct. Rep. 2016, 11, 18–24. [Google Scholar] [CrossRef] [PubMed]
- Hilt, E.E.; McKinley, K.; Pearce, M.M.; Rosenfeld, A.B.; Zilliox, M.J.; Mueller, E.R.; Brubaker, L.; Gai, X.; Wolfe, A.J.; Schreckenberger, P.C. Urine Is Not Sterile: Use of Enhanced Urine Culture Techniques to Detect Resident Bacterial Flora in the Adult Female Bladder. J. Clin. Microbiol. 2014, 52, 871–876. [Google Scholar] [CrossRef]
- Wolfe, A.J.; Brubaker, L. “Sterile Urine” and the Presence of Bacteria. Eur. Urol. 2015, 68, 173–174. [Google Scholar] [CrossRef] [PubMed]
- Ruiz-Ripa, L.; Gómez, P.; Alonso, C.A.; Camacho, M.C.; Ramiro, Y.; de la Puente, J.; Fernández-Fernández, R.; Quevedo, M.Á.; Blanco, J.M.; Báguena, G.; et al. Frequency and characterization of antimicrobial resistance and virulence genes of coagulase-negative staphylococci from wild birds in Spain. Detection of tst-carrying S. sciuri isolates. Microorganisms 2020, 8, 1317. [Google Scholar] [CrossRef]
- Couto, I.; Santos Sanches, I.; Sá-Leão, R.; de Lencastre, H. Molecular characterization of Staphylococcus sciuri strains isolated from humans. J. Clin. Microbiol. 2000, 38, 1136–1143. [Google Scholar] [CrossRef]
- Sousa, M.; Silva, V.; Silva, A.; Silva, N.; Ribeiro, J.; Tejedor-Junco, M.T.; Capita, R.; Chenouf, N.S.; Alonso-Calleja, C.; Rodrigues, T.M.; et al. Staphylococci among Wild European Rabbits from the Azores: A Potential Zoonotic Issue? J. Food Prot. 2020, 83, 1110–1114. [Google Scholar] [CrossRef]
- Vanderhaeghen, W.; Piepers, S.; Leroy, F.; Van Coillie, E.; Haesebrouck, F.; De Vliegher, S. Identification, typing, ecology and epidemiology of coagulase negative staphylococci associated with ruminants. Vet. J. 2015, 203, 44–51. [Google Scholar] [CrossRef]
- Gómez-Gamboa, L.; Núñez-Chacín, D.; Perozo-Mena, A.; Bermúdez-González, J.; Marín, M. Staphylococcus aureus con resistencia múltiple a los antibióticos (MDR) en un Hospital de Maracaibo–Venezuela. Kasmera 2016, 44, 53–65. [Google Scholar]
- Iorgoni, V.; Stanga, L.; Iancu, I.; Degi, J.; Popa, I.; Gligor, A.; Orghici, G.; Sicoe, B.; Dreghiciu, I.C.; Purec, D.; et al. Multidrug-Resistant Escherichia coli Associated with Respiratory and Systemic Infection in a Domestic Rabbit in Romania: First Confirmed Case. Antibiotics 2025, 14, 929. [Google Scholar] [CrossRef] [PubMed]
- Degi, J.; Herman, V.; Iancu, I.; Badea, C.; Zaha, C.; Mergheș, P.E.; Iorgoni, V.; Florea, B.-A.; Cristina, R.T.; Degi, D.M. Antimicrobial Susceptibility Patterns of Staphylococcus spp. Isolates from Mastitic Cases in Romanian Buffaloes from Western Romania. Antibiotics 2025, 14, 537. [Google Scholar] [CrossRef] [PubMed]
- Dégi, J.; Morariu, S.; Flo, G. Future Challenge: Assessing the Antibiotic Susceptibility Patterns of Staphylococcus Species Isolated from Canine Otitis Externa Cases in Western Romania. Antibiotics 2024, 13, 1162. [Google Scholar] [CrossRef] [PubMed]
- Dégi, J.; Herman, V.; Iancu, I.; Pascu, C.; Florea, T.; Dascălu, R. Carriage of Multidrug Resistance Staphylococci in Shelter Dogs in Timișoara, Romania. Antibiotics 2021, 10, 801. [Google Scholar]

Disclaimer/Publisher’s Note: The statements, opinions and data contained in all publications are solely those of the individual author(s) and contributor(s) and not of MDPI and/or the editor(s). MDPI and/or the editor(s) disclaim responsibility for any injury to people or property resulting from any ideas, methods, instructions or products referred to in the content. |
© 2025 by the authors. Licensee MDPI, Basel, Switzerland. This article is an open access article distributed under the terms and conditions of the Creative Commons Attribution (CC BY) license (https://creativecommons.org/licenses/by/4.0/).
Share and Cite
Florea, B.; Morar, D.; Văduva, C.; Simiz, F.; Velescu, S.; Kracunovic, C.; Iorgoni, V.; Nistor, P.; Degi, J.; Iancu, I.; et al. First Report of Multidrug-Resistant Staphylococcus sciuri Isolated from the Urinary Bladder of a Domestic Rabbit in Romania: A Case Study. Antibiotics 2025, 14, 1089. https://doi.org/10.3390/antibiotics14111089
Florea B, Morar D, Văduva C, Simiz F, Velescu S, Kracunovic C, Iorgoni V, Nistor P, Degi J, Iancu I, et al. First Report of Multidrug-Resistant Staphylococcus sciuri Isolated from the Urinary Bladder of a Domestic Rabbit in Romania: A Case Study. Antibiotics. 2025; 14(11):1089. https://doi.org/10.3390/antibiotics14111089
Chicago/Turabian StyleFlorea, Bogdan, Doru Morar, Cristina Văduva, Florin Simiz, Simina Velescu, Corina Kracunovic, Vlad Iorgoni, Paula Nistor, Janos Degi, Ionica Iancu, and et al. 2025. "First Report of Multidrug-Resistant Staphylococcus sciuri Isolated from the Urinary Bladder of a Domestic Rabbit in Romania: A Case Study" Antibiotics 14, no. 11: 1089. https://doi.org/10.3390/antibiotics14111089
APA StyleFlorea, B., Morar, D., Văduva, C., Simiz, F., Velescu, S., Kracunovic, C., Iorgoni, V., Nistor, P., Degi, J., Iancu, I., Herman, V., Pocinoc, A., & Dumitrescu, E. (2025). First Report of Multidrug-Resistant Staphylococcus sciuri Isolated from the Urinary Bladder of a Domestic Rabbit in Romania: A Case Study. Antibiotics, 14(11), 1089. https://doi.org/10.3390/antibiotics14111089

